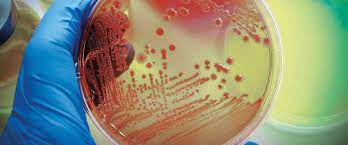
Pathology & Microbiology

Pathology & Microbiology
PATHOLOGY
Shrimann Superspeciality Hospital has its in house, state-of-art laboratory services, catering to all the needs of the patients, with the utmost integrity. We offer 24*7 operational support to the medical teams in the hospital. At Shrimann Super Speciality Hospital we believe, quality is never an accident, it is always the result of high intention, sincere efforts, intelligent direction and skilful execution.
Our Hospital is a pioneer for different state-of-the-art technology initiatives in the state.We are dedicated to the need of understanding the basis of disease and apply our understanding to improve medical diagnosis and treatment of patients. Our consultant pathologists often participate in the clinicopathological and oncological meetings with different specialities.
MICROBIOLOGY
We are committed to improve and advance the diagnosis of infectious diseases.Our microbiologists are trained in effective and advanced diagnostic methods for the detection and testing of microbial pathogens. We provide expert assistance in the test selection, test results, interpretation and additional testing when needed.





